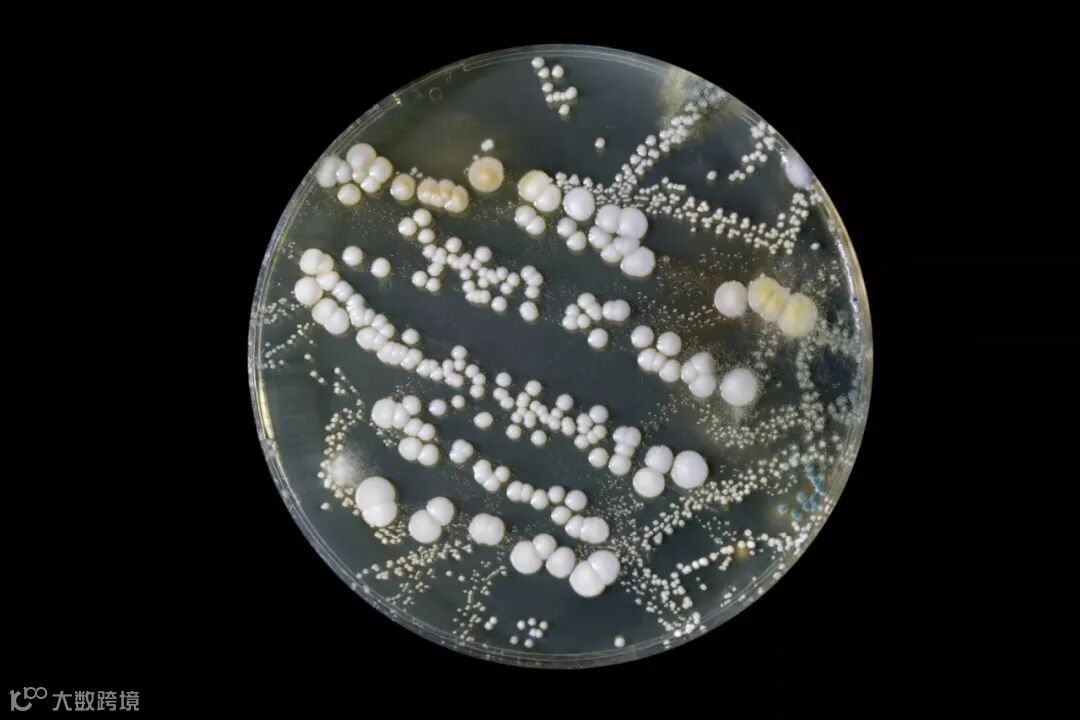

一.为什么要使用抑菌剂?
体外诊断试剂产品在制备、使用或储存过程中,容易因为长菌而影响产品的稳定性,特别是用于监测血细胞分析仪的校准品和质控品以及免疫、生化领域的检测试剂盒和校准质控。这些产品的组分多为细胞、抗体、抗原和酶等生物源性物质,并且在保存基质中通常会添加葡萄糖、BSA等营养和蛋白保护成分,这些组分为微生物的生长提供了良好环境。为了避免试剂产品长菌,最常用的方法是通过添加抑菌剂来抑制微生物的和生长,从而提高产品的稳定性。
bacteria growing exponentially in a Petri dish. Wladimir Bulgar / Science Photo Library / Getty Images
二.抑菌剂的作用原理是什么?
干扰微生物的酶系,破坏其正常的新陈代谢,抑制酶活性;
使微生物的蛋白质凝固和变性,干扰其生存和繁殖;
微生物细胞膜的渗透性,抑制其体内酶和代谢产物的排除,导致其失活。
三. 抑菌剂的种类有哪些?
抑菌剂又称为防腐剂,种类繁多,大致可以分为有机酸及其盐类、醇类、对羟基苯甲酸酯类、有机汞类、抗生素类、叠氮化物类、阳离子类、甲醛缓释体类和异噻唑啉酮类抑菌剂。
| 类型 | 作用原理 | 具体物质 | 特性用途 |
| 有机酸及其盐类 | 有机酸及其盐类抑菌剂主要通过降低体系的pH, 抑制微生物细胞内的酶活性及其代谢合成,从起到抑菌的作用。 |
苯甲酸及其盐(苯甲酸钠)、山梨酸及其盐(山梨酸钾)、乙酸及其盐(脱氢乙酸钠)、丙酸及其盐(丙酸钙)和乳酸及其盐(乳酸钠)等 | 有机酸及其盐类抑菌剂的毒性较小, 通常用于食品防腐剂。 |
| 醇类 | 醇类可以改变细胞膜的通透性,甚至破坏细胞膜的完整性,使细胞内容物外泄,并且能够使酶和蛋白变性降低活性,从而达到防腐的目的。这类抑菌剂除本身抑制细胞活性外,由于羟基的存在还可以与其他抑菌剂形成不稳定的醇类复合物,并利用羟基与细胞膜的亲和性,透过细胞膜进入内部,从而提高其他抑菌剂的抑菌效果。 |
乙醇、丙二醇、丁二醇、苯甲醇、苯乙醇、苯氧乙醇等 | 醇类防腐剂安全性较高、刺激性低,但大部分醇类需要高浓度才能抑菌,低浓度通常作为其他抑菌剂的增强剂。 |
| 对羟基苯甲酸酯类 | 对羟基苯甲酸酯类抑菌剂是一种广谱型抑菌剂,其抑菌作用主要依赖于对羟基结构,这种结构可改变微生物细胞膜的通透性,使细胞内容物外泄,同时使细胞中蛋白质变性失活。 | 尼泊金甲酯、尼泊金乙酯和尼泊金丙酯等 | 这类抑菌剂与咪唑烷基脲、苯氧乙醇有良好 的协同效果,低毒,油溶性好, 并具有较好的热稳定性,在化妆品中应用广泛。 |
| 有机汞类 | 有机汞类抑菌剂可以与微生物细胞内的巯基反应,使细胞内酶失去活性,降低其呼吸代谢,从而抑制微生物的生长。 | 硫柳汞,又称为硫汞柳酸钠 | 广泛用于生物制品以及疫苗等药物制剂的抑菌剂。 |
| 抗生素类 | 抗生素是一种药物类抑菌剂,其抑菌机理主要包括: 一是作用于细菌细胞壁,抑制其细胞壁的合成,导致细胞壁松弛、变形和裂解,从而抑制细菌生长; 二是抑制细菌核糖体的合成,导致蛋白质合成障碍,通过改变细菌代谢过程而起到抑菌作用。 |
喹诺酮抗生素(氧氟沙星、环丙沙星,主要针对于革兰氏阴性细菌)、大环内酯类抗生素(阿奇霉素等,可有效杀灭球菌、厌氧菌、军团菌及支原体等病原体)、β-内酰胺类抗生素(青霉素、头孢菌素等,可有效抑制革兰氏阳性菌、革兰氏阴性球菌和嗜血杆菌等)、氨基糖苷类抗生素(庆大霉素等,主要针对革兰氏阴性杆菌)。 | 抗生素具有抑菌作用的同时,也会产生严重的抗药性问题。因此,抗生素的使用是一把双刃剑,在实际应用过程中也受到了严格的限制。 |
| 叠氮化物类 | 叠氮化物可以抑制细胞色素氧化酶及多种其他酶的活性, 并可导致细胞磷酸化及细胞呼吸异常。 |
最常用的叠氮化物防腐剂是叠氮钠 | 叠氮钠是体外诊断试剂中最常用的防腐剂之一,其性质稳定,可抑制细菌生长,但由于其含有氨基,会干扰辣根过氧化物酶、超氧岐化酶等多种酶,一般含有这些酶类的试剂不建议使用。叠氮钠有剧毒性,遇高热或剧烈震动会发生强烈爆炸,所以其使用受到严格管制。 |
| 阳离子类 | 阳离子抑菌剂带正电,而微生物常带有负电荷,这类抑菌剂能够吸附微生物,使其聚集成团造成细胞膜堵塞封闭,使菌体呼吸代谢停止。 | 苯扎氯铵、氯己定、聚六亚甲基胍等。 | 这类抑菌剂具有较强的抑菌和杀菌性能, 必须保证体系中无阴离子表活的存在, 同时排斥多种螯合剂,常作为医用杀菌剂来使用。 |
| 甲醛缓释体类 | 甲醛缓释体类抑菌剂可以缓释甲醛,甲醛可透过细胞膜渗透进细胞内部,同时使蛋白质中的氨基、巯基和嘌呤碱基的氮杂环烷基化,导致蛋白质变性失活,从而起到抑菌防腐效果。 | 咪唑烷基脲、双(羟甲基)咪唑烷基脲和DMDMH等季铵盐也可以通过释放甲醛起到抑菌作用,也属于甲醛缓释体类抑菌剂,如氯化3-氯烯丙基六亚甲基四胺。 |
可与尼泊金酯类、IPBC等配合使用,增强其防腐效果 常用于高级营养化妆品 |
| 异噻唑啉酮类 | 异噻唑啉酮类抑菌剂可以改变细胞膜的通透性,导致部分细胞内容物外泄,但并不破坏细胞膜的完整性,并且能够与细胞内含巯基的酶反应形成二硫化物,使酶失去活性,同时在形成二硫化物的基础上继续反应形成硫代酰氯,同细胞内大分子相互作用,导致细胞失活。 | 异噻唑啉酮类 5-氯-2-甲基-4-异噻唑啉-3-酮( CMIT) 和2-甲基-4-异噻唑啉-3-酮(MIT) |
适用于 Western blot、免疫组化、免疫荧光、ELISA、生化缓冲液、水浴锅用水、清洗剂、化妆品等检测试剂的抑菌和防腐 |
体外诊断产品中用于防止微生物生长的传统防腐剂并不理想
-
硫柳汞价格昂贵,而且由于含有汞,被列为有毒物质,需要处理。它在包括日本在内的一些国家被禁止使用; -
叠氮化钠(NaN3)在通常使用的水平上主要是生物静态的,而不是生物杀灭剂,因此它可能不能有效地控制产品中的微生物; -
抗生素提供针对特定微生物群的保护,而不是广谱保护; 抗生素联合使用扩大了保护范围,但联合使用变得复杂和昂贵,保护仍然不完整;
出于投入高、监管严、风险大等多方因素考虑,硫柳汞,叠氮化钠等传统抑菌剂的使用逐渐成为困扰实验室和企业发展的难题。
—GBCBIO® Buffpro 300—
GBCBIO® Buffpro 300 作为替代硫柳汞和叠氮钠的优秀抑菌防腐剂在水溶液中的稳定性好,对试剂的颜色无干扰;毒性远远低于硫柳汞和叠氮化钠,且有良好的生物降解能力,不会对环境造成污染,杀菌广谱高效,是一种专用于体外诊断试剂的高效防腐剂和抑菌剂,可用于各种体外诊断试剂、酶制剂、缓冲液等含水试剂产品中,且适用于 Western blot、免疫组化、免疫荧光、ELISA等检测试剂的抑菌和防腐。
-
抑菌性强:Buffpro 300 对细菌和真菌、和霉菌均有抑菌效果, 低剂量时即有很好的抑菌防腐效果且持续长效。 -
兼容性广:Buffpro 300 不含金属离子,适应众多体系,与体系中的关键酶或诊断指示剂兼容,不会抑制抗体结合。 -
稳定性高:适用pH范围广(pH2.5~8.5),在各种缓冲溶液如Tris、TES或HEPES等pH7左右的溶液中化学稳定性好,推荐温度下未开封产品可以稳定保存三年以上 -
安全性好:在推荐的使用浓度下,无毒性,无健康风险;无生态蓄积性,环境友好。

<抑菌原理示意图>(Merck)
除了Buffpro 300 以外,Buffpro 150、Buffpro 950 也在体外诊断试剂、酶制剂、缓冲液、清洗液等含水试剂产品中具有显著防腐抑菌效果。
| 产品编号 | G6248 | G6258 | G6268 |
| 产品名称 | Buffpro 150 | Buffpro 300 | Buffpro 950 |
| 活性成分 | 1.5% CMIT/MIT | 3% CMIT/MIT | 9.5% MIT |
| 基质 | 水 | 丙二醇 | 水 |
| PH值 | 1.7-3.7 | 2.0-6.0 | 3.0-6.0 |
| 适用pH范围 | 2.5-8.5 | 2.5-8.5 | 2-12 |
| 推荐使用浓度 | 0.05-0.10% | 0.03-0.10% | 0.05-0.10% |
| 保质期 | 4年 | 3年 | 3年 |
|
|
优先推荐用于酸性溶液、化妆品、洗涤剂及家庭用品等 | 优先推荐用于酸性到弱碱性的溶液,如各种缓冲液、生化试剂、校准品等 | 优先推荐用于pH>9.5的碱性溶液,及血细胞或血型检验试剂的保存 |
Buffpro 150:http://www.gbcbio.cn/Product/G6248-50ml.html
Buffpro 300:http://www.gbcbio.cn/Product/G6258-50ml.html
Buffpro 950: http://www.gbcbio.cn/Product/G6268-50ml.html
声明:部分图源网络,侵权联删
整合了网上诸多资料,因此未能一一注明出处。如有侵权,请联系作者删除。
品牌优势
捷倍斯生物可以提供专业和完善的核酸分离纯化解决方案,有硅胶柱法、磁珠法与溶液直接法的核酸纯化产品,在二代测序的样品前处理方面有着专业的技术与积累,有完善的针对唾液、血液与血浆等样品的保存、运输与高通量核酸纯化等整套的解决方案。 在诊断试剂原料方面,捷倍斯生物可以提供生物染色剂、高端的表面活性剂、显色底物、生物缓冲剂以及酶制剂与其稳定剂等系列产品。

做值交往的人|做值得信赖的产品



